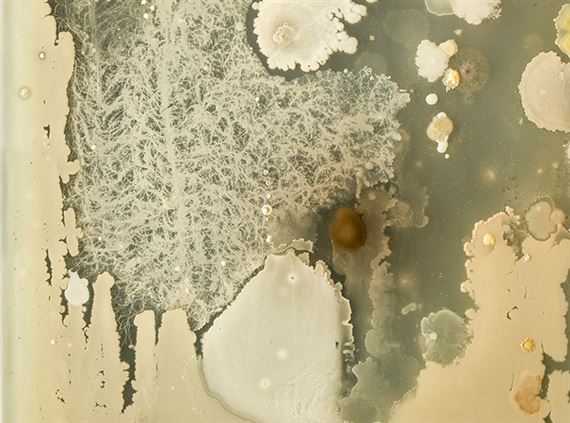
Hart House Collection: Works on View - Art Museum at the University of Toronto, Justina M. Barnicke Gallery

Hart House Collection: Works on View
The Hart House Permanent Collection had its beginnings in 1922 with the purchase of a work by A.Y. Jackson, one of the members of the then recently formed Group of Seven painters. A dominant force in the early 20th century history of Canadian art, the Collection encompasses now world-renowned works by members of the group and their wider circles across the country, including Tom Thomson, Emily Carr, Charles Comfort, David Milne and others, whose primary interests was in the representation of the Canadian landscape and wilderness.
In the mid-century century, the collection came to focus on the Montreal-based Automatists and the Toronto-based artists associated with Painters Eleven, whose works explored and promulgated abstraction.
Most recently, the Art Committee has focused on acquiring works by culturally diverse artists in a greater range of media, including artists who are at once engaged with but also counter prevailing canons and mythologies of identity and history in Canadian art. Inclusive of broader gender and cultural identities, as well as artistic forms, the current selection of works features Toronto-based artists such as Wendy Coburn, Erika DeFreitas, Jalani Morgan, Jon Sasaki, and Laurel Woodcock, as well as artists from across the country, including Stan Douglas, Ken Lum, Divya Mehra, Adrian Stimson, and many others.
Recommended for you
The Hart House Permanent Collection had its beginnings in 1922 with the purchase of a work by A.Y. Jackson, one of the members of the then recently formed Group of Seven painters. A dominant force in the early 20th century history of Canadian art, the Collection encompasses now world-renowned works by members of the group and their wider circles across the country, including Tom Thomson, Emily Carr, Charles Comfort, David Milne and others, whose primary interests was in the representation of the Canadian landscape and wilderness.
In the mid-century century, the collection came to focus on the Montreal-based Automatists and the Toronto-based artists associated with Painters Eleven, whose works explored and promulgated abstraction.
Most recently, the Art Committee has focused on acquiring works by culturally diverse artists in a greater range of media, including artists who are at once engaged with but also counter prevailing canons and mythologies of identity and history in Canadian art. Inclusive of broader gender and cultural identities, as well as artistic forms, the current selection of works features Toronto-based artists such as Wendy Coburn, Erika DeFreitas, Jalani Morgan, Jon Sasaki, and Laurel Woodcock, as well as artists from across the country, including Stan Douglas, Ken Lum, Divya Mehra, Adrian Stimson, and many others.
Artists on show
- Aba Bayefsky
- Adrian Stimson
- Arthur Edward Cleeve Horne
- Aviva Rubin
- Bill Vazan
- Carl Beam
- Carol Conde
- Charles Comfort
- Christian Nicholson
- Clark Cunningham
- David B. Milne
- David Milne
- Dawit L. Petros
- Deanna Bowen
- Divya Mehra
- Emily Carr
- Erika DeFreitas
- Evan Penny
- Fastwürms
- Gerald William Scott
- Greg Curnoe
- Group of Seven
- Hadley & Maxwell
- Harold Town
- Herman Heimlich
- Isabel McLaughlin
- Jack Leonard Shadbolt
- Jacqueline Gilson
- Jacques de Tonnancour
- Jalani Morgan
- Jean Paul Lemieux
- Jérôme Havre
- Joanne Tod
- Joe Fafard
- Jon Sasaki
- Karl Beveridge
- Ken Lum
- Kent Monkman
- Laurel Woodcock
- Lilias Torrance Newton
- Liz Magor
- Lynn Donoghue
- Lynne Cohen
- Malcolm Rains
- Meryl McMaster
- Micah Lexier
- Monica Tap
- Norval Morrisseau
- Osvaldo Yero
- Painters Eleven
- Rebecca Belmore
- Robin Collyer
- Roy de Maistre
- Scott Carter
- Scott McFarland
- Shelley Niro
- Sorel Etrog
- Stan Douglas
- Steven Evans
- Sylvia Hahn
- Wendy Coburn
- William Goodridge Roberts
- William Johnson Stapleton

 ARTISTS
ARTISTS
















